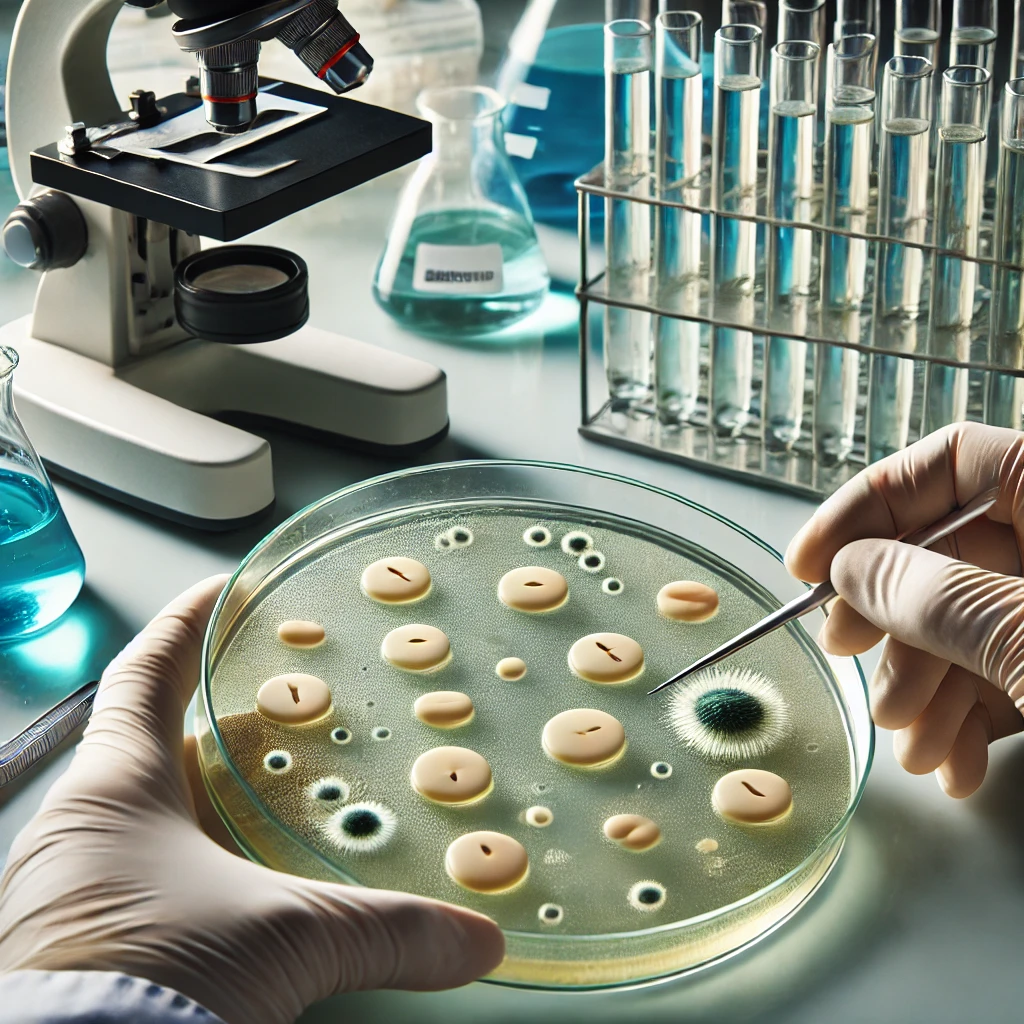

Why is antimicrobic sensitivity testing done?
a. To identify the bacteria causing an infection.
b. To determine what antimicrobials would be most effective for treating the intection
c. To determine what antimicrobials would be most effective tor toatimicrobiats the patient is susceptible to
d. All of the above
The correct answer and explanation is :
The correct answer is:
b. To determine what antimicrobials would be most effective for treating the infection.
Explanation:
Antimicrobial sensitivity testing (AST), also called antibiotic susceptibility testing, is performed to identify the most effective antimicrobial agents for treating bacterial infections. This test is essential in guiding clinicians to prescribe the right antibiotic, ensuring the best possible outcome for the patient while minimizing resistance development.
- Purpose of AST:
- The main goal of AST is to determine which antibiotics can effectively inhibit or kill a specific bacterial strain causing an infection.
- It helps in selecting the most appropriate treatment to improve patient outcomes.
- This test prevents the unnecessary use of broad-spectrum antibiotics, which can lead to antibiotic resistance.
- How AST is Performed:
- A sample is taken from the infected site (e.g., blood, urine, sputum, or wound swab).
- The bacteria are isolated and cultured in a laboratory.
- Different antibiotics are applied to see which ones inhibit bacterial growth.
- The results are interpreted based on the zones of inhibition or minimum inhibitory concentration (MIC).
- Importance of AST:
- It helps combat antibiotic resistance by ensuring targeted treatment.
- Reduces treatment failures by avoiding ineffective antibiotics.
- Assists in epidemiological surveillance by identifying resistance patterns.
- Protects patients from potential adverse effects of unnecessary antibiotic use.
In conclusion, AST plays a critical role in modern medicine, ensuring infections are treated effectively while minimizing the risk of antibiotic resistance. It is a fundamental step in patient care when dealing with bacterial infections.
Here is an image representing antimicrobial sensitivity testing in a laboratory setting:
Here is an image representing antimicrobial sensitivity testing in a laboratory setting. It shows a petri dish with bacterial colonies, antibiotic discs creating clear zones of inhibition, and a scientist analyzing the results using lab equipment.